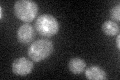
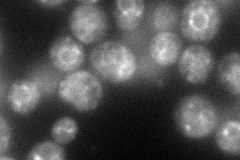
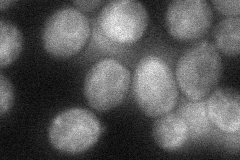
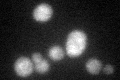

View description
Farnesyl cysteine-carboxyl methyltransferase, mediates the carboxyl methylation step during C-terminal CAAX motif processing of a-factor and RAS proteins in the endoplasmic reticulum, localizes to the ER membrane
Localization:
Intensity:
Fold change:
Significance:
-
C’ GFP library in SD
punctate:ER26.51 -
N' NOP1pr-GFP in SD
ER,punctate83.282 -
N' TEF2pr-mCherry in SD

ER,vacuole147.516 -
N' NATIVEpr-GFP in SD

below threshold22.2408 -
N' TEF2pr-VC and Cyto-VN in SD
ER35.918 -
C’ GFP library in SD+DTT
punctate.ER24.350.91No -
C’ GFP library in SD+H2O2

punctate.ER22.180.83No -
C’ GFP library in Starvation Media

punctate,ER19.920.75Yes -
C’ GFP library on the background of Pup2-DaMP

punctate:ER -
C’ GFP library on the background of CCT mutant

punctate:ER22.28640.840484No
